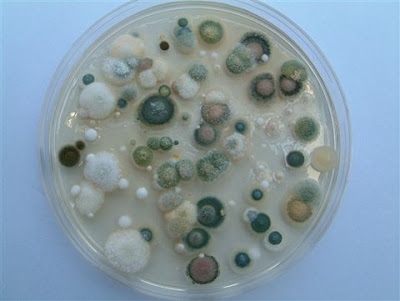

მალე პარიზს მივემგზავრები პრაღის გავლით.
ყველა წესით და კანონით, თუკი საერთოდ ამ ცხოვრებაში პარიზის მონახულება მომიწევდა, ამ მოვლენას წინ უნდა ხლებოდა ბევრი ისეთი, რომელიც ლოგიკური თანმიმდევრობით უნდა აღსრულებულიყო - უმნიშვნელოდან მნიშვნელოვანისკენ, იაფიდან ძვირისკენ, აუცილებელიდან ხუშტურისკენ.
მე კი ეს თანმიმდევრობა მერღვევა, ბოლო საოცნებო თავგადასაველი ისე მიხდება, რომ ჯერ ბევრი პრაგმატული საფეხური არ გამივლია (დღეს არ მყავს მანქანა, დასაბეჭდად გამზადებული წიგნები ვერ გამოვეცი, პატარა რემონტი ჩემი ოჯახის ყველა წევრს გვჭირდება თუნდაც გეგმიური). მე კი პარიზში მივდივარ.
ოქრო , ვერცხლი და ბრილიანტისა რა მოგახსენოთ და მე და ჩემს ცოლს კი "პარიზის ქორწილი" გვაქვს (ქორწინების 20 წლის თავი). მაშინ აქ თბილისში მშვენიერი ამინდი იდგა, დღეისგან განსხვავებით (ცივი ქარი ყმუის).
ევროპაში რეკორდულად ცივი ზამთარიაო, გვახარა კურიერმა. არაუშავს, გავუძლებ. იმედია თოვლი მაინც იქნება და თბილისის ფორუმზე პარიზის თემაში ხშირად ნახსენებ ნაგავს დაფარავს. ცოტა არ ოყოს გავბრაზდი ამ პარიზული ნაგვის ხშირი ხსენებით, ცოტა მაღლა აიხედეთ შვილოსან, ეს ულამაზესი ქალაქი უზარმაზარი შრომის, კულტურის, ცივილიზაციის, კარგი გემოვნების ზედნაშენია, ასე მგონია. ჩვენგან ჩასულები კი ნიშნისმოგებით რატომღაც ერთხმად ნაგავს "აფიქსირებენ". არ ვაპირებ გავღიზიანდე თუკი ქალაქში, რომელშიც წელიწადში 30 მლნ. ტურისტი ჩადის ბინძური დამხვდა, ჩემი სანახავი ობიექტები მიწიდან 20სმ-ზე მაღლა მეგულება.
მისურვეთ გამძლეობა 7 დღეში უამრავი სანახავი უნდა მოვიარო.
Wednesday, January 27, 2010
თბილისი -პრაღა- პარიზი 05:00
Posted by
cartwheel
at
12:14 AM
7
comments
Labels: ვინიგრეტი
Monday, January 25, 2010
ფილი ვარ თუ ფობი? რუსო მაქვს მხედველობაში

.
ამწინეებზე ჩემი ბლოგის ერთმა მართლა პატივცემულმა სტუმარმა კომენტში ჩამიწერა, რუსოფობი თუ იყავი არ მეგონაო.ჩემთვის ვფიქრობ.
რუსოფილი ვარ თუ რუსოფობი?
ვთქვათ თამაშის პირობა ასეთია, ან ფილი უნდა იყო, ან ფობი, შუალედური პოზიცია არ შეიძლება. ვის ბანაკში წავალ მე?
მოგეხსენებათ ფობია შიშს ნიშნავს, ფილია სიყვარულს.
ჩვენს რეალობაში რუსოფობია რუსულის სიძულვილად ტრანსფორმირდა, მაგრამ ძირი იგივე დარჩა - შიში.
მე რომ რუსოფობი ვიყო გავუგებდი ნოღაიდელსა და ოპოზიციას, იქნებ მათი აქტივისტიც გავმხდარიყავი. აბა წარმოიდგინეთ პოზიცია კაცისა ვისაც რუსეთის ეშინია. ის თვლის რომ რუსეთი მოვა და დაგიპყრობს, ქუჩების თავში და ბოლოში ბლოგპოსტებს ჩაგვიყენებს (გვახსოვს 20 წლის წინანდელი აპრილი), ყველას აგიმხედრებს, უფროსად მლიქვნელს დაგინიშნავს ძეშვილი გვარით. თვლი რომ საქართველო ვერასდროს გაერთიანდება და რუსეთს ყოველთვის ექნება სამხედრო უპირატესობა საქართველოს ტერიტორიაზე (როგორც ახლაა).
რაღა დამრჩენია, ნოღაიდელის იმედადღა უნდა ვათენო და ვაღამო.
ეხლა კი ფილია, სიყვარული. ერთი საათიც არ არის გასული რაც ფორუმზე ერთერთი ფორუმელის მიერ რუსული ინტერნეტ ფორუმებიდან ქართველებსა და საქართველოზე ამოკრეფილი "მარგელიტები" წავიკითხე, ყველა შეურაცხმყოფელი და ველიკოძერჟავული, ზიზღის პოეზია მოკლედ.
ამის მიუხედავად ვიტყვი, რომ მე საქართველოს გაერთიანების იმედი მაქვს (თარიღს არ ვასახელებ) და ეს აუცილებლად უნდა მოხდეს რუსების თანხმობით. იმედი მაქვს დღეს დაჩმორებული ე.წ. მეორე რუსეთის, რომელიც მჯერა რომ არსებობს. ანუ რუსოფილი მე ვყოფილვარ. რუსის წინააღმდეგ თუ საჭირო გახდა ვიბრძოლებ კიდევაც, მოვკლავ იმ მიზნით, რომ ამ ქვეყანამ თვითონ ჩაგთვალოს მებრძოლად, გულწრფელ სამშობლოს დამცველად, როგორიც მას მილიონები ჰყავს.
ყველაფერს გავაკეთებ ჩემი შესაძლებლიობის ფარგლებში, რათა რუსებმა თავის ფორუმზე ჩემი ომი "პინოკ-ად" არ მოიხსენიონ. გულწრფელად შევეცდები ამ ბეგემოტს თავისი 8 სმ-იანი კანით ტკივილი ვაგრძნობინო და არა ქავილი.
და ამ ჩემი ბრძოლის ადრესატი იქნება მეორე რუსეთი, რომელსაც მე პატივს ვცემ, და რომელიც დღეს გაყურსულია, გაგრაში წარსულ დიდებას დაუბრუნდა და ნებივრობს.
Posted by
cartwheel
at
12:59 PM
0
comments
Thursday, January 21, 2010
საჩუქარი იდეები პროგრამისტებს

1.
ვორდის ფაილის ზემოთ აწევისას ავტომატურად უნდა მოინიშნებოდეს მანამდე გაჩერებული გვერდის ქვედა კიდე, რათა აწევის მომენტში (მოძრაობაში) ხედავდე იმ კიდეს, რომელიც შენ უკვე წაიკითხე და აღარ გაინტერესებს, რათა ერთი მცდელობით გააჩერო გვერდი საჭირო სტროფთან.
2.
ბლოგერისა და ვორდპრესის საიტებზე თემების ჩამონათვალი უსიცოცხლო და არამიმზიდველია. მართალია ის იძლევა ინფორმაციას თუ რამდენი პოსტი მიუძღვნა ავტორმა ამ თემას (მაგალითად: უიკენდი (19), საზოგადოება (23), მუსიკა(14)),მაგრამ ეს ჩამონათვალი შეიძლება უფრო მიმზიდველი გახდეს, თუ თემები მიიღებს არა მშრალი ჩამონათვალის, არამედ ერთმანეთზე დალაგებული წიგნების გამოსახულებას, წიგნების სისქე შესაბამისობაში იქნება პოსტების რაოდენობასთან და ბუნებრივად განსხვავებული წიგნების თაროს ასოციაციას შექმნის.

კარგი დიზაინით უნდა გაკეთდეს, საიტის მფლობელს უნდა შეეძლოს წიგნების ინდივიდუალური დიზაინების შერჩევა ბევრი შაბლონიდან.
კარგი იქნება თემების შესარჩევად საიტის სტუმართათვის. "წიგნების" ავტორობა წაახალისებს თავად ბლოგსაიტების მფლობელებსაც განაგრძონ ბლოგერობა და გააფართოვონ ლიტერატურული ასპარეზი.
Posted by
cartwheel
at
2:19 PM
0
comments
Labels: ვინიგრეტი
საპირველაპრილო ანდერძი.
ეს ანდერძი საპირველაპრილო მხოლოდ იმიტომაა, რომაა რომ საპირველაპრილოა, თორემ ტყული არ არის, რეალურად გამოსადეგარია.
აუცილებლად მოიწყე წიგნის საკითხავი განათება საწოლთან.
არ იქონიო ტელევიზორი საძინებელ ოთახში.
თუ ვარჯიში გეზარება და ნებისყოფის ჩართვაც სხვა დროისთვის გაქვს გადადებული ივარჯიშე ერთი სიმღერის განმავლობაში დაბანვის ან შხაპის წინ.
ფრჩხილები ბანაობის შემდეგ დაიჭერი (რბილია და ადვილი),
წვერი ბანაობისას გაიპარსე სანამ შამპუნით გაქაფული გაქვს თავი (დროს იგებ და მოხერხებულია, საპარსი ქაფიც არ ჭირდება, თანაც შამპუნის ექსპოზიცია იზრდება და შესაბამისად მისი სამკურნალო (თუ აქვს) ეფექტიც.
იხმარე აბანოს ხალათი (ყოველ დაბანაზე 3 მაზალო წუთს აგაცილებს), თუ აბაზანაში ჩაწოლა ოცნებად ან თუნდაც სურვილად გაქვს, მიიღე ის - ფეხზე მდგომარე დაბანვისას, თუკი წყალს არ გაუშვებ, დარწმუნდები რომ აბაზანა თითქმის ნახევრამდე ივსება ცხელი წყლით. ასე რომ თუ აბაზანას მიიღებ ჩვეულაბრივი დაბანვის ხარჯს 10%-ით გადააჭარბებ, მეტით არა.


ჭამე ბევრი ყველი, როცა ბალახი ლორთქოა, პამოდორი როცა მწიფეა, ხილი როცა მწიფეა. ანუ ნუ დაიხარჯები ახალშემოსული დეფიციტური ხილბოსტნეულისათვის, დაელოდე დროს, როცა გემრიელი და სასარგებლო გახდება.
იქონიე დემისეზონური ტანსაცმელი, ორივეჯერ გამოგადგება გაზაფხულზეც დას შემოდგომაზეც, თანაც როგორც წესი ელეგანტურია.
ნუ იყიდი მოჭერილ ფეხსაცმელს იმ იმედით რომ გაიწევს.
ჭამე ბევრი ცილა, ადრე დაგანაყრებს და ზედმეტი საჭმელის შეჭმისაგან დაგიცავს (ნაწილობრივ მაინც).
იყოლიე არანაკლებ 3 ბავშვისა.
იყავი ცხოვრებასთან ბალანსში.
Posted by
cartwheel
at
1:31 PM
1 comments
Labels: ვინიგრეტი, ძირს პათეტიკა
Tuesday, January 19, 2010
შუალედური ანდერძი


ათეისტი ვარ. ჭიები შემჭამენ. სიკვდილი აუცდენელი რეალობაა, ის მოვა.
როდის? უცნობია ჯერ.
მე თვითონ მის მოახლოებას არ ვაპირებ, არც ასაკით მიწევს, მაგრამ დღეს ისეთ იშტაზე ვარ შუალედური ანდერძი უნდა დავწერო. (ხომ არის შუალედური არჩევნები).
არა იმიტომ, თითქოს ცელი დამენახოს სადმე, არამედ იმიტომ, რომ ვთვლი რომ ყველა ზრდასრულმა ადამიანმა უნდა დაწეროს პერიოდულად, მიუხედავად იმისა რა ქონების ოპატრონია და აპირებს თუ არა სიკვდილს.
თანაც რომანტიული მიზეზი მაქვს ანდერძის დასაწერად - პარიზში მივფრინ-მოვფრინავ. ეკუთვნის ამ მოვლენას ჩემგან დაფასება. სენტიმენტებმა არ გძლიონ, იცოდეთ რომ ამ პოსტს თვითკმაყოფილების ზენიტში ვწერ.
ქონებას აქ არ დავწერ, ნოტარიუსთან იხილეთ (სინამდვილეში ჯერ არ ვაპირებ არც სანოტარიუსო ანდერძის წერას).
აქ სხვა ქონების განკარგვის დალაგება მინდა (ჩემს შემდეგაც და ახლა ჩემთვისაც).
ეს ჩემი სუბიექტური ქონებაა. ეს ისაა, რაც სიკვდილის შემთხვევაში უპატრონოდ მრჩება და არ მინდა რომ გაქრეს.
სუბიექტური ქონება იმიტომ დავარქვი, რომ ის ჩემი პირადია, პირადი პოზიციის ჟილკის, მონდომების შედეგია და არა პროფესიულ-სოციალური.
მხედველობაში ის მაქვს, რომ არც ჩემი პროფესია და კარიერა და არც ოჯახურ-მრავალშვილიანი (3 მრავალია?) სტატუსი არ მთხოვდა დამეხარჯა დრო და ფული, მქონოდა სამყაროს შეცვლის ჩემი გეგმა და ამ გეგმის შესაბამისად ჩემს გარშემო, ჩემი შესაძლებლობის ფარგლებში შემეცვალა გარემო თუნდაც ერთი გოჯით, ოღონდ სწორი მიმართულებით.
კი შევცვალე. ერთი ადამიანის კვალობაზე ცუდი შედეგი არ არის.
არ მაქვს მხედველობაში ის, რომ ჩემი პროფესიის შესაბამისად ადამიანიების სიცოცხლის შენარჩუნებაში, პროცესში რომელიც სტრუქტურას (სავადმყოფო) ადამიანებს (სამედიცინო პერსონალი, ბევრი კარგი ადამიანი) და აპარატურას (ძვირიან, ძალიან ძვირიან აპარატურას) თხოულობს , მეც მიმიღია მონაწილეობა და ბევრჯერ მთავარი საქმე (ფიზიკურიც და საპასუხისმგებლო გადასაწყეტიც) მე გამიკეთებია.
ასეთ საქმეს რომ მოგანდობენ ნემსის ყუნწში უნდა გაძვრე, ცხრა პირი ტყავი გადაიტყავო და უნდა შეასრულო, ეს მარტივი არჩევანია. ეს პროფესიულ-კარიერული სტანდარტული ბილიკია, ამიტომ მასზე არ ვილაპარაკებ.
სხვა მაქვს საქმელი-საანდერძო.
შუა გზაში მაქვს მიტოვებული საქმეები, რომელთაც თქვენ უნდა გაუძღვეთ. ეს საქმეები მომავალში უფრო მეტ მნიშვნელეობას შეიძენენ, ან უკვალოდ დაიკარგებიან თუ არ მიეშველეთ. სხვისმა ბამბამ რამდენიც უნდა იმდენი იჩხრიალოს, მე ჩემი ოქროს ბედი მაწუხებს, ჩუჩუნებს, არ ჩხრიალებს, არადა ოქროა.
ბერნის ხელშეკრულების შესაბამისად თქვენ , ჩემო შვილებო *უფლება გაქვთ გამოსცეთ "დედის კალენდარი" და "ერთიდან 7 წლამდე" პირველი გამოცემიდან 50 წლის განმავლობაში. "ძიძის სახელმძღვანელოც" ნაწილობრივ ჩემი კოპირაითითაა გამოცემული.
საიტი bavshvi.ge, რომელშაც დღეს 60 მკითხველი აკითხავს ყოველდღიურად ასევე მისახედია.
ანდერძად არა, რჩევად კი გეტყვით - შეგიძლიათ გამოსცეთ ფორუმზე ჩემი თემა "შემეკითხეთ, გიპასუხებთ" ოღონდ წინასიტყვაობაში უნდა მიუთითოთ რომ "მამა პრეზიდენტის პირადი ექიმი კი იყო, ოღონდ თქვენთვის არასდროს უთქვამს ათანხმებდა თუ არა მიშასთან თავის პოსტებს" (ინტრიგაა ერთგვარი).
თუკი მოგენატროთ, სევდა-კაეშანს ნუ მიეცემით, ჩემი ბლოგი წაიკითხეთ, ან ფორუმზე ნახეთ ჩემი თემები.
და კიდევ, ნუ შემიცოდებთ, ბედნიერი კაცი ვარ და იმედია სიცოცხლის ბოლო წამს იგივე გრძნობა მექნება.
იმედია იმ მომენტში მადლობელი ვიქნების ღმერთის რომ ვიყავი და რომ მყავდით, თანაც კარგები.
ცოტა ხანი არ მიცოცხლია, სიცოცხლეს "წუთისოფლად" ანუ უსამართლოდ ხალმოკლედ არ ვთვლი, პირიქით ჩემი ორიენტირია სიტყვა "საუკუნე" და არა სიტყვა "წუთისოფელი" .ადამიანისთვის 100 წელი იმდენად დიდი დროა, რომ იმის უკან უკუნია, დავიწყებული უკუნი, იმის წინაც უკუნია, წარმოუდგენელი უკუნი. მართალია ცივილიზაციამ კაცობრიობას მეტი სიცოცხლის ამბიცია გაუჩინა, მაგრამ მე ვთვლი, რომ ხანგრძლივი და შინაარსიანი ცხოვრება უკვე მაქვს ზურგსუკან. წინ ბონუსია.
P.S.ქელეხი არ გადამიხადოთ თუ რატომღაც ოდესმე მთვრალმა ავარია გავაკეთე და მოვკვდი.
ნუ დამმარხავთ, ლეშად ვეგდო ტყეში თუკი რატომღაც ოდესმე სიმთვრალის გამო ავარია გავაკეთე, მოვკვდი და სხვაც შევიწირე.
P.P.S....
ჩემო შვილებო *
ჩემი შვილები ამ ბლოგს არ წყალობენ ჯერ, ასე რომ თუკი მართლა ისინი წაიკითხავენ ამ სიტყვებს, დიდი ალბათობით მართლაც მონატრებული ვეყოლები:(.
Posted by
cartwheel
at
6:00 PM
0
comments
Labels: ვინიგრეტი, მე ათეისტი, სააკაშვილი, ძირს პათეტიკა
Monday, January 18, 2010
მარო ბაბო


ეს წერილი თუ ვედრება-წერილი ბებიაჩემმა (ბაბომ და არა ბებიამ, ბებია მეორე მყავდა) თურმე 1941 წელს დაწერა, როცა შვილი ყივანახველით ავად ჰყავდა, ქმარი კი (საშა ბაბუ) ომში ახალი გაწვეული (ფრონტზე არ გაუწვევიათ, ლენინაკანში წაიყვანეს ოფიცრად როგორც სამხრეთ საზღვარზე შეღავათი სკოლის დირექტორთათვის.
იმ ხალხთაგან კი, ვისაც ბაბო ღმერთს ავედრებს, დღეს მხოლოდ ჩემი დეიდაღა არის ცოცხალი.
მან აღმოაჩინა ეს წერილი შარშან, 2009 წელს, და გაიხსენა, რომ დედამისი ხშირად ჩაიხედავდა ამ ქაღალდში და ბუტბუტებდა თავისთვის.
ბაბოს ზრუნვას დღეს მე ვღებულობ და ჩემი შვილები.
მადლობა მას.
აცხონოს უფალმა მისი შენავედრი ხალხი იმქვეყნად.
თუ გაგიჭირდეს ჩემი ღმერთი ახსენეო, მეუბნებოდა ხშირად. მატყობდა ათეისტობას ალბათ.
მარო ბაბოს ღმერთო მიშველე, გვიშველე.

Posted by
cartwheel
at
8:52 PM
3
comments
Labels: მადლობა, სადღეგრძელო
პარიზ-პარიჟ-პაღიჟ


თვის ბოლოს პარიზში მივფრინავ. 


მივფრინავთ.
საქორწილო მოგზაურობაში, ოღონდ იგივე ცოლთან
თანაც ქორწინებიდან 20 წლის საიუბილეოდ.
მისი იდეაა. გადაწყვიტა, დაგეგმა
.
და დამითანხა.
მართალია ერთი კვირა ვუძალიანდებოდი, არ ვიყავი თანახმა ამ "ბელკა ვ კალისე" რეჟიმის დათმობისათვის, ხარჯისათვის.
მქონდა რაღაც რიდი ოჯახის, მეგობრების, თანამშრომლების, ქვეყნის წინაშე, რომ ჩემთვის მიმეცა ამის უფლება.

ალბათ ისიც მოქმედებდა, რომ პარიზს როცა ამბობ პარიჟს გულისხმობ და სადღაც უთქმელად ტვინში ტრიალებს პაღიჟ.
P.S.პარიზ-პაღიჟის ანალოგიით ქუთაისიც თავში ქუთეისად ტრიალებს და ამ მნიშვნელოვან ქართულ ქალაქს შინაარსს უფუჭებს. ალბათ ამიტომაც გვეხამუშება პარლამენტი ქუთაისში.
პაღიჟი კი ქალაქ პარიზს სხვა მიმართულებით უცვლის შინაარსს, ის მდედრობითი სქესის ელეგანტურ საოცნებო მისამართად იქცევა.
Friday, January 15, 2010
ფეისბუკი

ფეისბუკზე დიდი ხნის წინ დავრეგისტრირდი.
დავრეგისრტირდი და .. მისი არსებობს საფუძვლიანად დავივიწყე.
დღეს საკუთარი შვილის წინამძღოლობით ფეიბუკზე "ექსკურსია" მოვაწყე. აღმოვაჩინე, რომ ჯერ კიდევ ვარ დარეგისტრირებული, რომ ხალხს ჩემთან დამეგობრების თუ "E-დამეგობრების" შეკითხვები გამოუგზავნია, მე კი უპასუხოდ მყოლია ამდენ ხანს. სორრი.
ამიერიდან შევეცდები ფეისბუკის რეგისტრირებული წევრიდან მომხმარებელ წევრად ვიქცე.
ვნახოთ რა გამოვა.
აქამდე ბლოგსპოტი სრულად აკმაყოფილებდა ჩემს ჭიას, ახლა არ ვიცი მისი გემოვნება რამდენად მოითხოვს ფეისბუკს.
ერთია, წინასწარ ვიტყვი.
ტაბუების შემქმნელი ნატურა ვარ.
ოღონდ ეს ტაბუები მხოლოდ ჩემთვის მინდა. თუმცა ჩემი შექმნილი ტაბუები ნაწილობრივ გავრცელებული მაქვს ჩემს ოჯახზეც (ცოლშვილზე).
ეს ტაბუებია:
არასდროს მქონია რუსული მენიუ მობილურში,
არასდროს მქონია რუსული ვინდოუსი,
არცერთი რუსული საიტი არ არის ჩემს ფავორიტებში,
არცერთი რუსული სიმღერა არ არის ჩემს MP3-თეკაში,
არასდროს შევსულვარ "ადნაკლასნიკებში",
არასდროს მითქვამს ახალი წლის შემდეგ, რომ რუსულ არხებზე კარგი გადაცემები იყო და ჩევნი კი არ ვარგოდა,
ჩემს ტელევიზორში რუსული არხები (ნათარგმნი დისქავერები არ ითვლება) 17-ის შემდეგ მაქვს.
ტაბუ არა, მაგრამ წიკებში (აკვიატებულ უცნაურობებში) გადის აგრეთვე ჩემი პოზიციაც:
-არ დავრეგისტრებულიყავი აფხაზეთში ნაომრად და შესაბამისად არ ამეღო ყოველწლიურად დაახლოებით 1500 ლარი, რომელიც დღგ-ში მიდის.
-დავრჩე დღევანდელი ხელისუფლის გულშემატკივრად, იმის მიუხედავად, რომ ჩემი შემოსავალი შევარდნაძის დროიდან ციფრებით უმნიშვნელოდ გაიზარდა, მსყიდველობითი უნარით კი შემცირდა.
ფეისბუკში ჩემი ავატარის ისტორიაა.
შემოიხედეთ.
www.facebook.
Posted by
cartwheel
at
1:51 PM
6
comments
Labels: საზოგადოება, ხალხი
Tuesday, January 12, 2010
როგორ დავიმსახუროთ ნობელის მშვიდობის პრიზი?
როგორ დავიმსახუროთ ნობელის მშვიდობის პრიზი?
პირველი მოსაზრება, რომელიც ამ შეკითხვაზე პასუხად მოგივათ ალბათ იქნება:
იმისათვის რომ ნობელის მშვიდობის პრიზი მოიპოვო უნდა:
-ცხოვრების მთავარ მიზნად მშვიდობის დამყარება დაისახო.
-უნდა ჩადგე მეომარ მხარეებს შორის და მათ მშვიდობისაკენ მოუწოდო საკუთარი სიცოცხლის რისკის ქვეშ დაყენების ფასად.
-შენი მიზნების უმთავრესი ორიენტირი უნდა იყოს მშვიდობა .
-მსოფლიომ უნდა გაგიცნოს როგორც მშვიდობისთვის მებრძოლი
-მსოფლიო უნდა დარწმუნდეს, რომ მშვიდობა შენთვის მთავარი ღირებულებაა.
-შენ რეალურად უნდა მიაღწიო მშვიდობას, ან განმუხტო ფეთქებადსაშიში სიტუაცია.
-ომის დროს მოახერხო მსხვერპლის მაქსიმალურად შემცირება
თანახმა ხართ, ხომ?
არადა ამ ჩამონათვლიდან მხოლოდ ორი პასუხია სწორი.
დანარჩენი არ არის საჭირო, უმნიშვნელოა.
ეს ორი პასუხია:
-შენ რეალურად უნდა მიაღწიო მშვიდობას, ან განმუხტო ფეთქებადსაშიში სიტუაცია.
-ომის დროს მოახერხო მსხვერპლის მაქსიმალურად შემცირება.
ყოველ შემთხვევაში, ჩემი შეფასებით ასე ფიქრობს ნობელის პრიზების გამცემი კომიტეტი.
საქმე ისაა რომ ამ კომიტეტს (და მე მიმაჩნა რომ ამ კომიტეტის პოზიციის უკან მთელი განვითარებული სამყაროს პოზიცია ისახება) მშვიდობის პრიზის გადასაცემად ერთი უთქმელი კრიტერიუმი აქვს.
ეს უთქმელი, ნაგულისხმევი კრიტერიუმი ცოტა არ იყოს ძნელი გადმოსაცემია, მაგრამ მე მაინც შევეცდები.
ჯერ შესავალი:
გადავხედე ნობელის მშვიდობის პრემიანტებს და აღმოვაჩინე, რომ მათი უმრავლესობა ცხოვრების ნახევარი იბრძოდა. იბრძოდა იდეისთვის, თავისუფლებისთვის, თანასწორობისთვის, იბრძოდა დამპყრობის, მჩაგვრელის, უზურპატორის, გაბატონებული წყობის წინააღმდეგ. ისინი გულწრფელნი იყვნენ თავის ბრძოლაში, არ შეშინებიან არც საკუთარი და არც სხვისი სიცოცხლის საფრთხეში ჩაყენებას.
ყველა მათგანს უმთავრეს მიზნად ბრძოლის გამარჯვებით დასრულება ჰქონდა მიზნად და არცერთ მათგანს მშვიდობისკენ მოწოდებებით არ გაუთქვამს სახელი.
მებრძოლებსა და ნობელიანტებს შორის განსხვავება განვითარების დონეშია. ნობელიანტები განვითარების ერთი სპირალური მარყუჟით მაღლა დგანან სისხლისმსმელ ტირანებსა და ტერორისტებზე.
მაგრამ ყვალა ნობელიანტს აქვს შენარჩუნებული იმდენი პრინციპულობა, მიზანდასახულობა და მსხვერპლისათვის მზადყოფნა თავისი ძირითადი (არა მშვიდობის, არამედ სხვა სოციალურ-პოლიტიკური) მიზანის მისაღწევად, რომ მსოფლიო მათ არა მშვიდობისთვის მებრძოლად, არამედ მათი პრინციპებისა და ღირსებისათვის უკომპრომისო მებრძოლად იცნობს.
იასირ არაფატი და ნელსონ მანდელა ათწლეულების განმავლობაში იყვნენ აღიარებულები ტერორიზმის მამებად, მათ ბრძოლის მოგება შეძლეს, მათი ორიენტირები არ შეცვლილა. ისინი არ დანებდნენ.
ისინი განვითარდნენ და შეძლეს თავისი ცხოვრების მიზანი არ შეეცვალათ ისე დაეძლიათ ზიზღი, შიში, აგრესა და მტერთან მაგიდასთან მიმსხდარებს გადაეწყვიტათ მომავალი.
იცით ალბათ რომ ნობელის მშვიდობის პრიზის ნომინანტად ჰიტლერიც ჰყოლიათ წარდგენილი.
ეს ფაქტი პირველად რომ მოვისმინე, ჩავთვალე რომ ნორვეგია მაშინ,ჯერ კიდევ მეორე მსოფლიო ომის გაჩაღებამდე ტერორში ჰყავდა გერმანიას და ამ ნომინირებით ნორვეგიელები ძლიერ მეზობელს ელაქუცებოდნენ, მაგრამ ახლა ვთვლი, რომ ნობელის მშვიდობის პრიზის კომიტეტმა მაშინ ჰიტლერის უნარი დააფასა პირველი მსოფლიო ომის შემდეგ დაქუცმაცებული და დაბეჩავებული გერმანიისათვის უომრად დაებრუნებინა ღირსება და ენერგია.
ო, ეს სიტყვაც ამოძვრა - ღირსება.
მე ვთვლი რომ ის უცილობელი, უთქმელი და ნაგულისხმები კრიტერიუმი, რითაც ადამიანი "მშვიდობის პრემიის" ნომინანტი და ლაურეატი ხდება, ღირსებაა.
ის უფრო მეტადაა იმპერატიული კატეგორია, ვიდრე თვით მშვიდობისმიყვარულობა.
ოღონდ საჭიროა ამ ღირსებისათვის მებრძოლმა მოღვაწემ შეძლოს ურთულესი დილემის ქვეშ ღირსების დაუკარგავად უმცირესი დანაკარგით დააღწიოს თავი კატასტროფულ მსხვერპლს.
ჰიტლერმა ეს ვერ და არ შეძლო.
ქართველებს ერთი ნომინანტი გვყავს მშვიდობის პრიზის მისაღებად, მას ჯერ არ დაუმტკიცებია მსოფლიოსთვის რომ მშვიდობის მტრედია (ეს მას არც მოეთხოვება), მას არც ჩაუთვლია რომ საკუთარი ძირითადი მიზანი "მშვიდობის პრიზისათვის" უნდა შეეწირა,
მისი საქმიანობა ჯერ კიდევ გრძელდება და ყოველ წელს ახალი დრამატულ მოსახვევს გადის. რამოდენიმეჯერ შეძლო გაემარჯვა უმცირესი მსხვერპლით (ვარდების რევოლუცია, აჭარა, კოდორი), რამოდენიმეჯერ მოზომილი ძალდასტანებით (კორუფცია, 7 ნოემბერი), მისი ბიოგრაფიის მთავარი გადაწყვეტილება კი ჯერ ჯერობით ორია:
"სამხრერთ ოსეთში" შესვლა და იქიდან გამოსვლა.
ეს ორივე გადაწყვეტილება ორი კატეგორიის ნაზავია - ღირსებისა და მშვიდობისმოყვარულობის.
მე მგონი ჯერ ადრეა ორივე ამ ქმედების შეფასება, მოვლენები ჯერ კიდევ ვითარდება.
მას ჯერ აქვს შანსი ნობელის პრიზი მიიღოს მსშვიდობის დარგში - ეს მხოლოდ იმ შემთხვევაში მოხდება თუ ღირსებას არ დაკარგავს და უსისხლოდ გაიმარჯვებს.
თვითონ ამ გზით მიდის, რას იზამს სამყარო მის ირგვლივ?
ერთმა ნობელიანტმა მას ხელი უნდა შეუწყოს.
ბარაკ ობამამ მშვიდობის პრიზი არა მშვიდობის დამყარებისათვის, არამედ ახალ რეალობაში (აგრესიული რუსეთი მსოფლიო ბატონობის გეგმებით) ღირსეული და ამავე დროს მშვიდობიანი პოზიციის დაჭერისთვის მიიღო.
მას საქართველო რუსეთისთვის რომ გადაებარებინა ღირსებას დაკარგავდა, 
ნობელის კომიტეტი მშვიდობისმოყვარეობას კი არ დაუფასებდა, ობამას ქვეშაფსიობით თავზარდაცემული რუსეთის შემდეგ აგრესიას დაელოდებოდა.
მოწოდება მოქმედებისთვის
მტერს არ მოსწონს შენი ღირსება? შეინარჩუნე ჯერ ღირსება და შემდეგ მშვიდობა
ობამას ნობელი- რუსების რეაქცია, ლოგიკური რეაქცია რუსებისთვის.
Posted by
cartwheel
at
1:47 PM
0
comments
Labels: ადამიანები, ვინიგრეტი, საზოგადოება
Sunday, January 10, 2010
ანიკერიდი

ცივილიზაცია მას შემდეგ დაიძრა, რაც კაცობრიობამ ინტელექტუალური სიმდიდრის შენახვა, გამრავლება და დაცვა შეძლო.
ბნელი შუასაუკუნეების წინ ადამიანებმა ბერძნულ-რომაული ანტიკური ეპოქა გამოიარა.
ეს პერიოდი გაცილებით მაღალი განვითარების იყო ჰომო საპიენსის ტალღოვან ისტორიაში, ვიდრე მას შემდეგ მოყოლილი ფეოდალიზმი თავისი ტახტისათვის ბრძოლებითა და მემკვიდრეთა მიერ ძმების თვალების დათხრით.
შუა საუკუნეებში ანტიკური ისტორია აღარც ახსოვდათ, არ იცოდნენ , რომ ადამიანი და სოციუმი ისეთი განვითარებილი შეიძლება ყოფილიყო, როგორიც მათმა წინაპრებმა უკვე გამოიარეს ბერძნული დემოკრატიის სახით.
ჩვენს წელთაღრიცხვამდე მე-4 საუკუნეში, როცა თავისი "იდეალური სახელმწიფო წყობის" გასავრცელებლად სიცილიაში (სირაკუზში) საპატიო სტუმრად მყოფი პლატონი
იქაურმა ტირანმა დიონისემ დაატყვევა და მონად გაყიდვა დაავალა თავის ჯარისკაცებს, ის ბერძენმა ვაჭარმა ანიკერიდმა გამოისყიდა, პლატონის მეგობრების მიერ პლატონის გამოსახსნელად შეგროვილი ფული პლატონს გადასცა და უთხრა, თავისუფალი ხარ, ეს ფული კი შენია, მოიხმარე როგორც მოგესურვოსო, პლატონმა მიწა იყიდა გმირი აკადემის საუფლოში და კაცობრიობის ისტორიაში პირველი აკადემია დააარსა.
ეს უანგარო ხარჯი ინტელექტის გამოსახსნელად და დასაფინანსებლად ჩვენს წელთაღრიცხვამდე მე-4 საუკუნეში იქნა გაღებული.
რამდენიმე იდეალისტი ადამიანის სამოქალაქო გმირობამ კაცობრიობას აკადემია დაუტოვა.
აკადემია როგორც სიტყვა და როგორც ინსტიტუტი..png)
მადლობა ეკუთვნით და ხსოვნა.
მაშ ასე
1.-ანიკერიდი, ვაჭარი, რომელმაც თავისი ფულთ სირაკუზელი ჯარისკაცებისგან პლატონი გამოისყიდა და თავისუფლება აჩუქა.
2.პლატონის უსახელო მეგობარი, მომელთაც პლატონის დატყვევების ამბის გაგების შემდეგ მის გამოსახსნელად ფული შეკრიბა.
3.პლატონის უსახელო მეგობარი, მომელმაც პლატონის დატყვევების ამბის გაგების შემდეგ მის გამოსახსნელად ფული გაიღო.
4.პლატონის უსახელო მეგობარი, მომელმაც პლატონის დატყვევების ამბის გაგების შემდეგ მის გამოსახსნელად ფული გაიღო.
5.პლატონის უსახელო მეგობარი, მომელმაც პლატონის დატყვევების ამბის გაგების შემდეგ მის გამოსახსნელად ფული გაიღო.
6.პლატონის უსახელო მეგობარი, მომელმაც პლატონის დატყვევების ამბის გაგების შემდეგ მის გამოსახსნელად ფული გაიღო.
7.პლატონის უსახელო მეგობარი, მომელმაც პლატონის დატყვევების ამბის გაგების შემდეგ მის გამოსახსნელად ფული გაიღო.
8.პლატონის უსახელო მეგობარი, მომელმაც პლატონის დატყვევების ამბის გაგების შემდეგ მის გამოსახსნელად ფული გაიღო.
9.პლატონის უსახელო მეგობარი, მომელმაც პლატონის დატყვევების ამბის გაგების შემდეგ მის გამოსახსნელად ფული გაიღო.
3.პლატონი, რომელმაც მოულოდნელად ნაჩუქარი თავისუფლება და ფული იმაში გამოიყენა, რომ უფასო სასწავლებელი - აკადემია დააარსა.
დღევანდელი პოსტის გმირად კი ანიკერიდს, ანუ ანიკერის ძეს ვაცხადებ.
Posted by
cartwheel
at
7:14 PM
6
comments
Labels: მადლობა, ძირს პათეტიკა
Friday, January 8, 2010
Stephen William Hawking

Stephen William Hawking
დისქავერი მეოთხე ნომრად მყავს ტელევიზორში და შესაბამისად ხშირად ვუყურებ. ეს კაცი რამდენიმე გადაცემაში გამოჩნდა.
დისქავერის თითოეული გადაცემა როგორც წესი მთელი მსოფლიოს მეგაექსპერტების კომენტარების თანხლებით მიმდინარეობს, ეს კაციც ერთერთი იყო, შავ ხვრელებზე, მეხუთე გამზომილებაზე, ჩვენი ცივილიზაციის სხვა პლანეტებზე გადატანის შესახებ მსჯელობდა.
ყურადღება იმით მიიქცია რომ... ინვალიდის სავარძელზე იჯდა, თუ იჯდა ქვია, ფაქტიურად ამ ადამიანისგან მხოლოდ თავია დარჩენილი, თავი, რომელიც ვერ ლაპარაკობს. (amyotrophic lateral sclerosis, also called Lou Gehrig's disease). ტრაქეოსტომიული მილიდან სუნთქავს, უფრო სწორედ აპარატი ასუნთქებს, მისი ხმა არ ჟღერს.
რაღაც ჯადოსნური რეზონატორ სიმულატორ- სინქრონიზატორის მეშვეობით მისი მცდელობა თქვას სიტყვა, მართლაც გამოითქმის სიტყვად, ოღონდ აპარატის მიერ. ეს ხმა კინორობოტის ხმას ჰგავს, მაგრამ რეალურ ცოცხალ უდიდეს (ცოცხალთაგან უდიდესს, როგორც www.answers.com-ში წერია) ფიზიკოსს ეკუთვნის.
ეს კაცი სტეფან ვილიამ ჰოკინგია. ის დღეს 68 წლის გახდა.
21 წლის ასაკში დაავადდა 3 წელი უნდა ეცოცხლა წესით, მაგრამ აჯობა ბედისწერასაც და მედიცინასაც.
ის არათუ კიდურებს, მიმიკურ კუნთებსაც კი ვერ იყენებს. მაგრამ მას უსმენენ. ნახეთ თქვენც და შემდეგი ვიდეოებიც მიაყოლეთ, თუ ხასიათზე იქენით, რა თქმა უნდა. 
ვინც ეს პოსტი ბოლომდე ჩაიკითხეთ, ესეც დაგაინტერესებთ
P.S.ახლა ვამეტებ, დღეს აღმოვაჩინე.
დისქავერის ახალი ტიხარი-სიმღერა აქვს, დაახლოებით ერთი თვეა ტრიალებს. დღეს აღმოვაჩინე რომ ეს კლიპი სტეფან ჰოკინგით მთავრდება.
იუთუბში ვნახე (კიდევ ერთი მადლობა იუთუბს),ინგლისურად გაცილებით კარგი მოსასმენია, სანახავიც კი, თანაც მონაწილეები (სხვადასხვა სერიალების გმირები) ახმოვანებენ.
ბოლო ბუმ დიადოს ეს კაცი ამბობს რობოტი პროგრამის მეშვეობით.
Posted by
cartwheel
at
10:59 PM
4
comments
Labels: ადამიანები, ექიმო, მადლობა
Wednesday, January 6, 2010
ვოლფრამი, სტეფან ვოლფრამი

ინტერნეტ სამყარო ელოდება ახალი საძიებო სისტემის - ვოლფრამ ალფას დაძვრას.
ამბობენ რომ გუგლზე მაგარი იქნება და მსოფლიოს მოიცავს.
ეს ჯერ კიდევ 2002 წელს იყო, როცა ფრთიანი ფრაზა დაფრინავდა - ინტერნეტში ყველაფერია, ყველა შეკითხვაზე პასუხს ნახავ.
დრო გავიდა და აღმოვაჩინეთ, რომ ინტერნეტში მართლაც ძალიან ბევრი და საჭირო ინფორმაციაა, მაგრამ ... ყველაფერს ვერ იპოვი, ყოველ შემთხვევაში ნებისყოფისა და დროის გარეშე ვერ იპოვი, ან სულაც ვერც ნებისყოფა და დრო გიშველის - ვერ იპოვი.
დღეს თვალი მოვკარი ამ საიტის ანონსს და მონახულება ერთი მიზნით გადავწყვიტე - სახელი მომეწონა ვოლფრამი.
ვოლფრამი ჯადოსნური საჩუქარია ყველა ჩვენგანისთვის, უმნიშვნელოვანესი მეტელია. მომავალ საუკუნეებში თუკი ვოლფრამის ნათებას მთლიანად ჩაანაცვლებს ნეონი და არგონი,
ვოლფრამის დიდებას ამით ბევრი არაფერი დააკლდება - ვოლფრამმა აჩუქა კაცობრიობას უსწრაფესი ტექნიკური აღზევების ერთი საუკუნე. ეს უკვე მოხდა.
დამაინტერესა იმ ადამიანების პროდუქტის ნახვა, რომელთაც თავის ქმნილებას ვოლფრამი უწოდეს.
აღმოჩნდა, რომ მთლად ასე რომანტიულად არ ყოფილა საქმე - პროგრამის შემქმნელი გვარადაა ვოლფრამი - სტეფან ვოლფრამი.
პირველი იმედგაცრუების შემდეგ მაინც გადავწყვიტე საიტის ტრილერის ნახვა ... თქვენც დახარჯეთ 13 წუთი ამ როლიკის სანახავად, უნდა ნახოთ ის თუ როგორია ინტერნეტი, რომელშიც "ყველა კითხვაზე პასუხია და ამ პასუხებს სწრაფად ღებულობ".
ეს ფაქტიურად უხელფეხო რობოტია.
სტეფან ვოლფრამმა ჩემს თვალში ვოლფრამების გვარი არ დააკნინა, შეინარჩუნა და იქნებ გააორმაგა კიდეც, გავიგებთ ამას ერთ 10 წელიწადში.
მანამდე კი ვოლფრამთან დაკავშირებულ ჩემს ოჯახურ ისტორიას მოგიყვებით.
2003 თუ 2004 წელს, როცა მამაჩემი ძველ ნადირექტორალ ენერგიას ვერ მოერია და უმუშევრობას ერთერთ კაფელ-მარმარილოს მაღაზიაში გაექცა "მენეჯერად", ჩვენს ტელევიზორებში ხშირად ტრიალებდა ორი სიუჟეტი
1. შემეცნებით-სგასართობი ვიქტორინა "ტაქსი", რომლის მონაწილე მგზავრებს, თუკი მძღოლი ზვიოს შეკითხვაზე პასუხი არ ჰქონდა, შეეძლო მოეთხოვა მანქანის გაჩერება და ახლომახლო გამვლელებისა თუ მაღაზიების გამყიდველებისათვის ეთხოვა კითხვაზე პასუხის გაცემა.
2. ამავე პერიოდში ახალცოცხიანი რევოლუციური მთავრობის ფინანსური სადამსჯელო სამსახურები პანტაპუნტით აპატიმრებდნენ დიდ და წვრილ მეწარმეებს ჟურნალისტისა და პროჟექტორიანი ვიდეოკამერების თანხლებით.
კურიერი ასეთი რეპორტაჟებით იწყებოდა და დასრულებამდე კიდევ ერთი ასეთი რეპორტაჟი ცხელცხელი შემოჰქონდათ.
ხოდა, შეუვარდნენ მანამდე მოწყენილ მამაჩემს კაფელ-მარმარილოს ცარიელ სალონში 5 შავებში ჩაცმული ამბალი თავზემოთ მფრინავი ვიდეოკამერის პროჟექტორით და ... იმის მაგივრად, რომ პირველ ახმახს ეთქვა " თქვენ დაპატიმრებული ხართ მოსახლეობისათვის ჭკუის სწავლების მიზნით", შეშინებულებმა ჰკითხა "რა მეტალი ანათებს ნათურაში?"
"რაა?"
""ტაქსში" ვარ ძიაკაცო, თუ გამოვიცანი მტვერსასრუტს ვიგებ"
"აააააა"
ამოისუნთქა მამაჩემმა და
უპასუხა -
"ვოლფრამი, რა თქმა უნდა ვოლფრამი, მაგრამ ედისონმა რომ გამოიგონა ის ნათურა ნახშირბადით ანათებდა"
???
"ვოლფრამი! უთხარი ვოლფრამი"
იმედია ის მტვერსასრუტი ჯერ კიდევ ზუზუნებს საჭიროებისას იმ მოგებული ახალგაზრდის ოჯახში.
თქვენ კი სხვა ტექნიკა გეკადრებათ - http://www.wolframalpha.com
Posted by
cartwheel
at
4:16 PM
3
comments
Labels: ადამიანები, მადლობა, ჯერარდაბადებული საქართველო
Tuesday, January 5, 2010
აგარ-აგარი და თერმოსტატი

დედამიწაზე ადამიანები გეომეტრიული პროგრესიით მრავლდებიან.
ისინი მალე შეუიარაღებელი თვალით იქნებიან დანახვადები კოსმოსიდან.
დედამიწა ალბათ, როგორც პეტრის ფინჯანში ჩნდება უხილავი ბაქტერიების კოლონები თვალით ხილული, ასევე შეიცვლება ადამიანის სიმრავლისა და აქტივობების შედეგად.
იმისათვის რომ დაადგინო თუ რომელი ბაქტერია შეჰყრია ავადმყოფს, ჩირქიან გლანდშენახები ჩხირით უნდა გაკაწრო პეტრის ფინჯანში მოთავსებული ჟელე - აგარ-აგარი და შემდეგ ეს ფინჯანი თერმოსტატში უნდა შედგა ერთი დღით მინიმუმ.
ანუ ცოტა,თვალით უნახავ ბაქტერიებს უნდა მისცე საკვები (აგარ-აგარი) და სითბო (თერმოსტატში მუდმივად 38 გრადუსია) და შედეგიც არ დააყოვნებს. ბაქტერიები გეომეტრიული პროგრესიით გამრავლდებიან და იმდენს იბარტყებენ, რომ თვალით საჩინონი, საცნობნი გახდებიან.
დღეს კაცობრიობა თერმოსტატში ვზივართ, და აგარ-აგარს უფასოდ გეახლებით, ამიტომაც ვმრავლდებით ასე გამალებით.
მაინც რა არის ადამიანთა მოდგმისათვის ის აგარ-აგარი, რიომლის ნიადაგზეც ადამიანთა კულტურა ასე ენერგიულად ვიზრდებით?
ჩემი პასუხია - ძროხა,ღორი,ქათამი,ხორბალი და შაქრის ჭარხალი.
დღეს ჩვენ მათ მოსაპოვებლად აღარგვიწევს სათითაოდ "შვილივით გამოზრდა" და "შრომის ოფლის მიწას წვიმება".
მუქთად გვაქვს.
Posted by
cartwheel
at
5:43 PM
5
comments
Labels: ვინიგრეტი, მე ათეისტი, ძირს პათეტიკა
